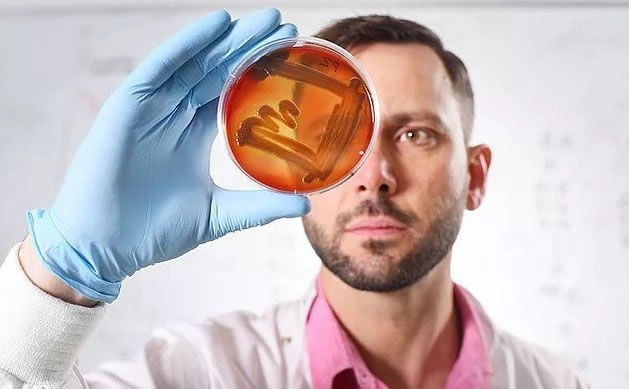

Is your car a health hazard?
For many people, those tiny crumbs of food buried around the car are a harmless hazard of eating on the move. But new research might make people think twice about leaving their car in its current state. The study has revealed that the inside of our cars is more than 50 percent dirtier than our bacteria-infested computer keyboards.

New research might make you think twice about leaving your car in its current state. The study has revealed that the inside of our cars is more than 50 percent dirtier than our bacteria-infested computer keyboards. Despite this, drivers still think cars are one of the cleanest possessions we own and only eight percent are able to identify vehicles as potential germ-carriers.
It also found our cars are 2144 percent filthier than our smartphones.DrJoe Latimer, a lecturer in antimicrobial resistance at the University of Salford, Greater Manchester, carried out the study by swabbing parts of 20 cars including the handbrakes, gearsticks and various nooks and crannies.
From these research studies, are you still believing that your car is safe and comfortable when you are driving it by using the traditional car wash? Why not try to change your car wash way and using the steam car wash machine to supply your family with a good driving experience?
Here comes our GOCLEAN steam car wash machine to solve your problem. It also named the bacterial and unpleasant killer. By using high-temperature steam vapor, the bacterial and dirt can be break up and then washed away by high pressure. Especially for the engine compartment and air-conditional, we can clean it well.




Leave A Comment
You must be logged in to post a comment.